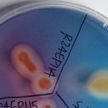

뉴스 · 콘텐츠
감소했던 육아휴직 '6+6' 효과에 역대 최대…母 줄고 父 늘었다
모두서치 12.17
이 대통령 "기술탈취로 1000억 벌었는데 20억 과징금 효과 있나…너무 싸다"
모두서치 12.17
경기도의회 고준호 의원, 고양시 찾아 ‘파주 광역소각장’ 진행상황 직접 확인
와이뉴스 12.17
‘쓰리백 효과’ 통했나… 그립 신규 크리에이터 유입, 전년 대비 77% 증가
스타트업엔 12.17
농촌진흥청, 국내산 비파잎 갱년기 여성 건강 개선에 효과 있어
경기연합신문 12.17
North Korean leader visits father's mausoleum
Aju Business Daily 12.17
더 플라자 PB 향기 제품 판매 20% 증가...유통 채널 확대 효과
투데이신문 12.17
정부 "G20, 성장동력 논의 주도해야…美, 효과성 제고 기여할 것"
아주경제 12.17
유럽 빅리그 일정 집중 효과… 해외축구, 12월 2주 차 스포츠 종목 관심도 1위
한스경제 12.17
호남권생물자원관, 식물 생장 촉진 세균 46종 신규 확인
연합뉴스 12.17
전세사기 걱정 끝? 이젠 네이버페이(Npay)에서 "'이 마크'만 확인하세요"
경인바른뉴스 12.17
[건강포커스] "심혈관 건강을 위한 생활습관, 암 환자 생존율 개선 효과"
연합뉴스 12.17
[속보] 손흥민 뛰어넘을 ‘MLS 역대급 이적’ 등장...‘비피셜’ BBC 확인! “레반도프스키 이적 긍정적”
인터풋볼 12.17
친자확인 프로그램 레전드
유머픽 12.17
'서울광장 스케이트장' 예약방법 이렇게...가격과 강습일정 '확인'
국제뉴스 12.17
이이경 측 "유재석 의심 안 했다" vs 유튜버 이진호 "사실 확인했다"…'놀면 뭐하니' 하차 논란 진실게임 점입가경
원픽뉴스 12.16
英 BBC 확인! 음바페, 법적 공방 끝 PSG에 승리... 프랑스 법원, "PSG는 1,058억 배상하라"
인터풋볼 12.16
SHINee’s Key Reveals Chicago Concert Highlights During North American Tour... Dominates the Stage with Stunning Visuals
메디먼트뉴스 12.16
센서타워 분석, 한국은 업비트 1위로 로컬 거래소 존재감 확인
한스경제 12.16
조국혁신당, 與 내란재판부법 수정에 "2인 3각이 가져온 시너지 효과"
모두서치 12.16